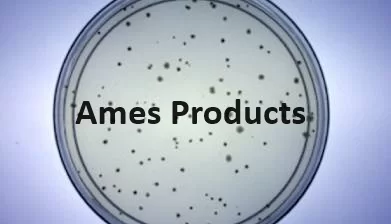

MOLTOX

MOLTOX® manufactures products used in mutagenicity tests. Our products and services for human risk assessment include MOLTOX® minimal glucose agar plates, top agars, Salmonella and E. coli tester strains, frozen and lyophilized S9, MUTAZYME™, NADPH-regenerating systems and positive control chemicals. MOLTOX® offers Salmonella and E. coli test kits in plate incorporation and fluctuation test formats. We also provide our SOS/UMU assay kit, which is designed for use with solid and aqueous environmental samples.
Featured Products
- Bacterial Tester Strains – Most commonly employed bacterial strains for use in mutagenicity testing are provided in convenient lyophilized disc format.
- Top Agars – MOLTOX® prepared media and media components are specifically formulated for use in bacterial mutagenicity assays.
- S9 and Regenerating Systems – MOLTOX® S9 preparations and cofactor reagents for use in metabolic activation studies are manufactured to rigorous standards of quality and performance and are used by leading industrial, government and academic laboratories worldwide.
- Positive Controls – CONTROLCHEM™ chemicals are obtained from major suppliers of research chemicals and are employed without further characterization or purification. Packaged quantities are precise within 1%.
- Minimal Glucose Agars – Our Minimal Glucose Agars are specifically formulated for use in bacterial mutagenicity assays.
- Phenotype and Growth Media – MOLTOX® prepared media and media components are specifically formulated for use in bacterial mutagenicity assays.
- Phenotype Confirmation Plates – For phenotype confirmation of Ames strains and E.coli WP2 derivatives.
- Nutrient Broth – Nutrient Broth is used for the cultivation of various nonfastidious microorganisms. The formulations which include Oxoid Nutrient Broth No. 2 are primarily used in the Ames assay.
- Nutrient Agar – Nutrient Agar is a general purpose medium for the cultivation and maintenance of nonfastidious organisms.
Product Categories
Blogs
Contact Us
The Krishgen support team strives to provide swift responses and resolution to your queries.